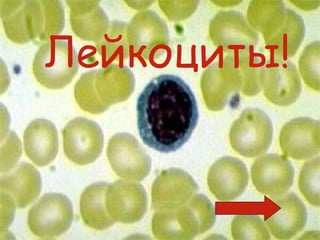
Лейкоциты!

Презентация описывает кровоснабжение организма человека и строение сердца, а также функции различных клеток крови. Основное внимание уделяется эритроцитам, тромбоцитам и лейкоцитам, включая их функции, состав и период жизни. Документ подчеркивает жизненно важную роль крови в транспортировке кислорода и питательных веществ, а также в защите организма от инфекций.